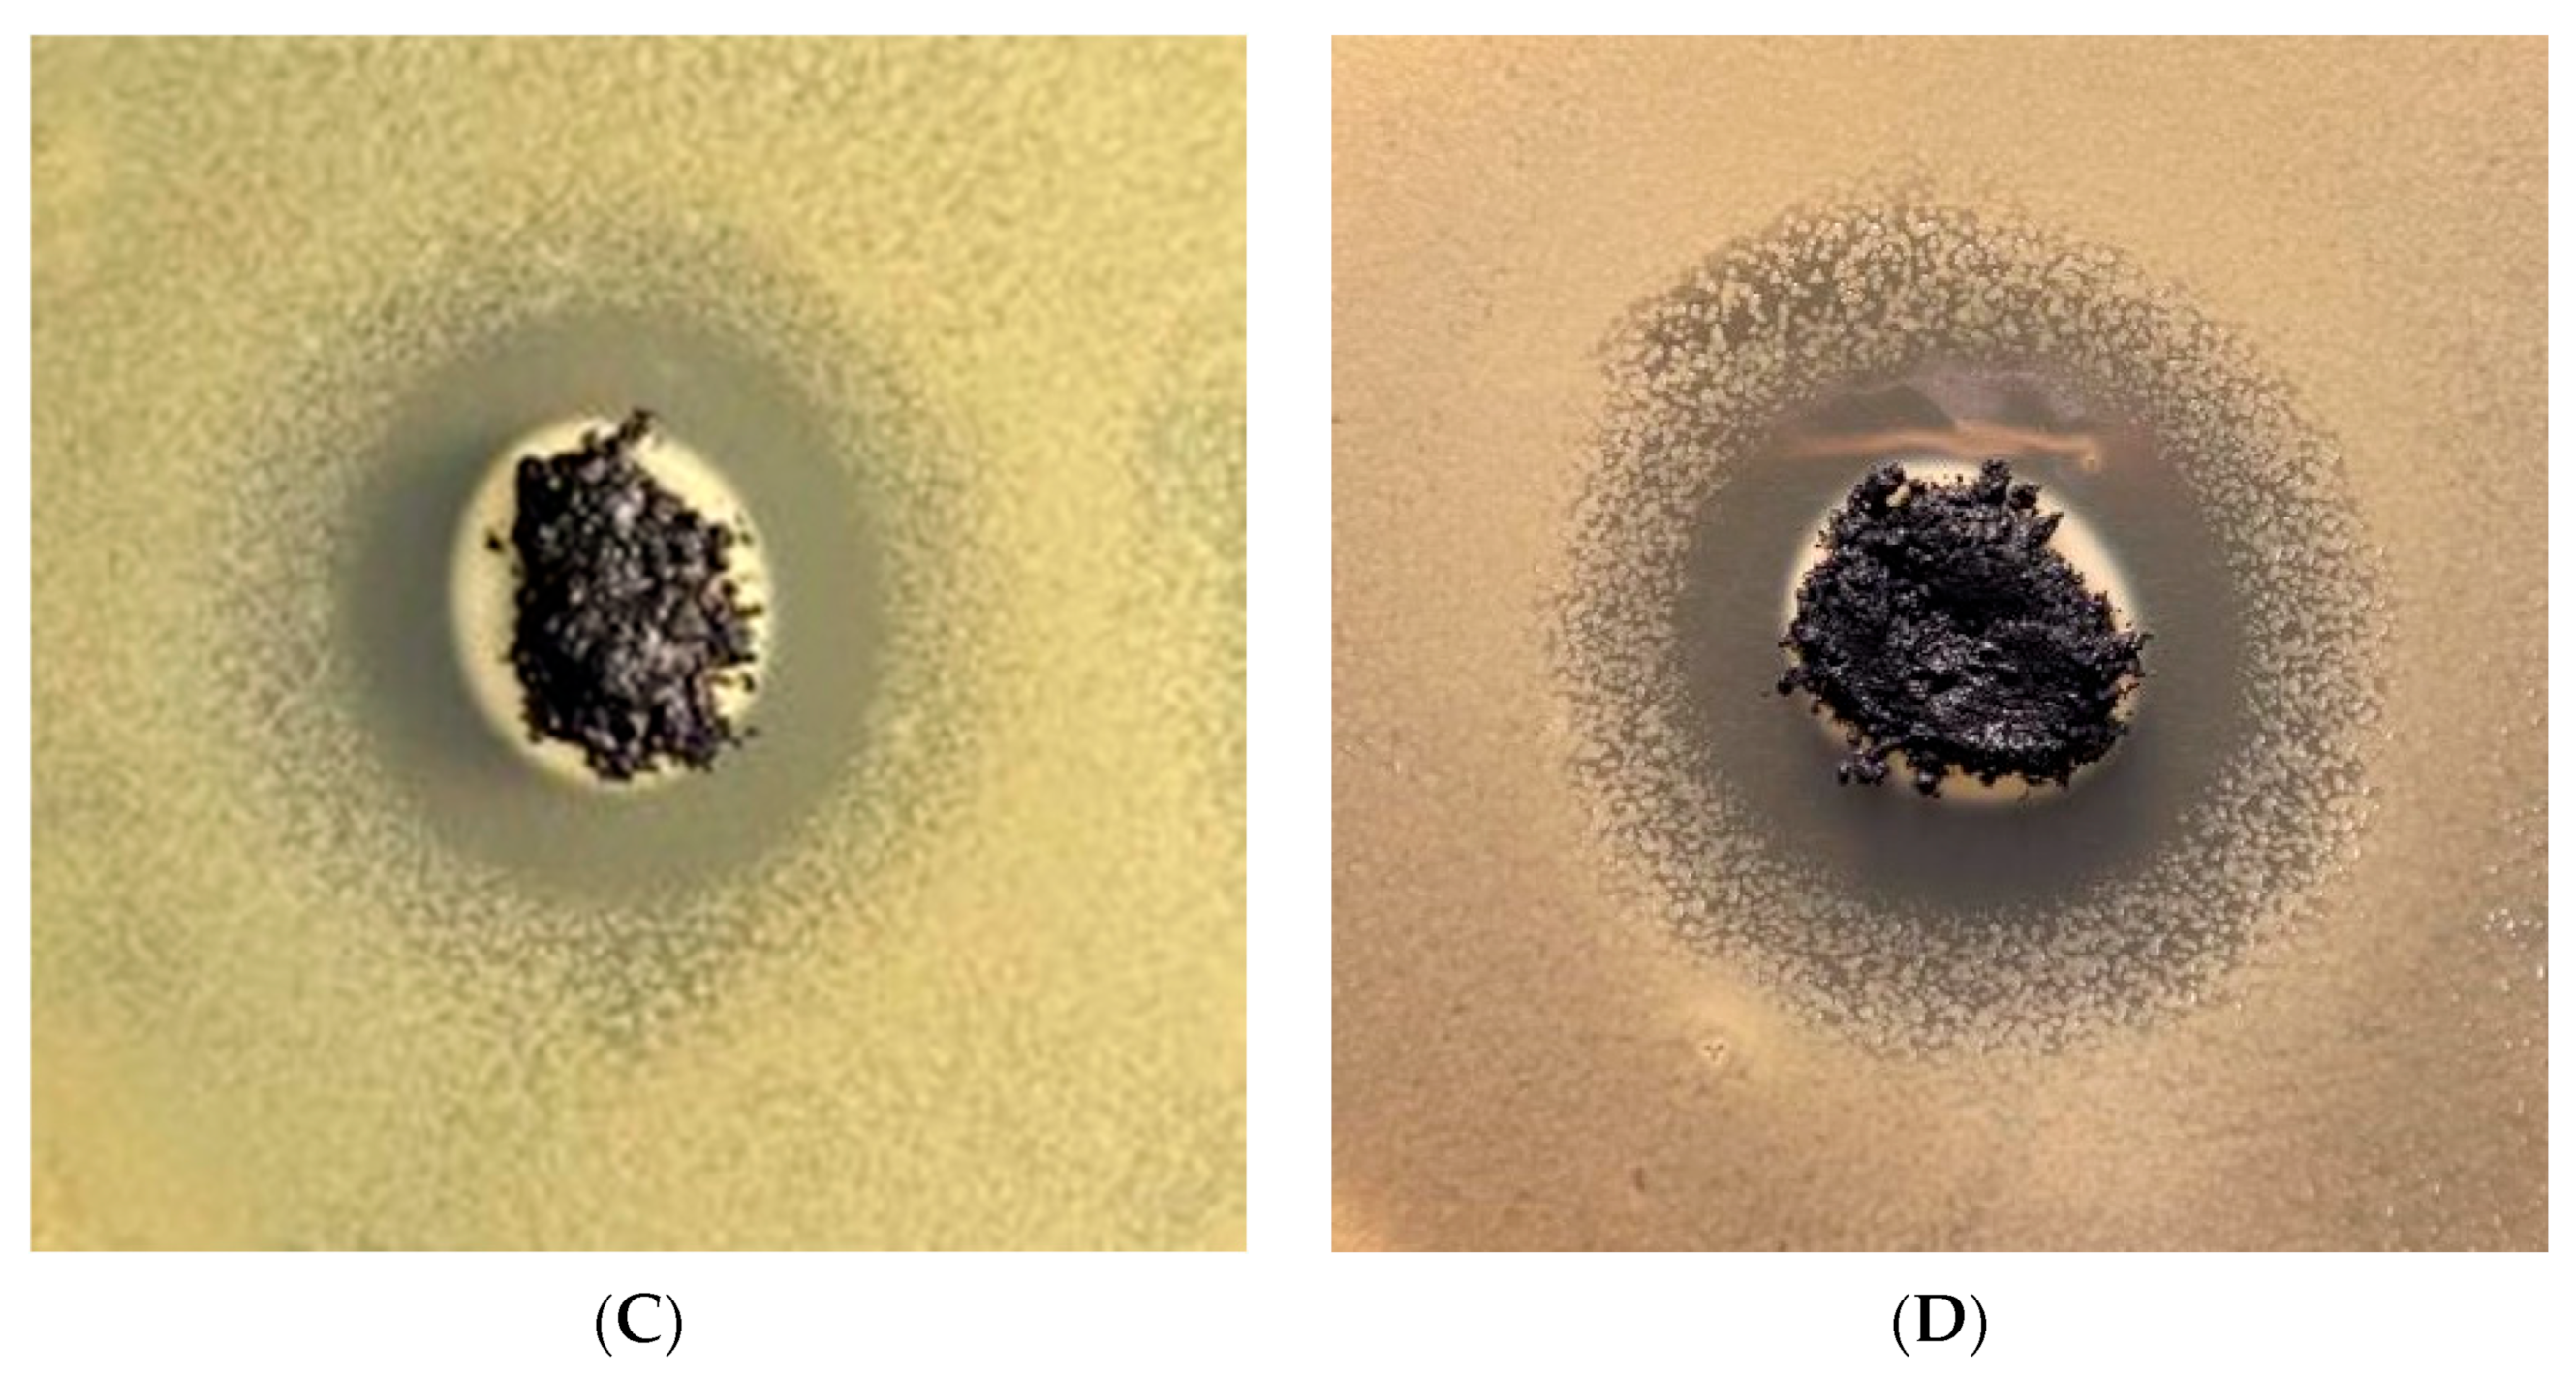
Applsci 14 06274 g010b

Synthesis, Characterization, and Antibacterial Activity of Graphene Oxide/Zinc Hydroxide Nanocomposites
Abstract
1. Introduction
2. Experimental Section
2.1. Materials
2.2. Synthesis of GO
2.3. Synthesis of GO/ZnOH Composite
2.4. Characterization of GO/Zn(OH)x Composite
3. Results and Discussion
3.1. Morphology
3.2. Elemental Mapping
3.3. X-ray Diffraction
3.4. XPS Results
3.5. Antibacterial Performance
4. Conclusions
Author Contributions
Funding
Institutional Review Board Statement
Informed Consent Statement
Data Availability Statement
Acknowledgments
Conflicts of Interest
References
- Rahman, S.; Sadaf, S.; Hoque, M.E.; Mishra, A.; Mubarak, N.M.; Malafaia, G.; Singh, J. Unleashing the promise of emerging nanomaterials as a sustainable platform to mitigate antimicrobial resistance. RSC Adv. 2024, 14, 13862–13899. [Google Scholar] [CrossRef] [PubMed]
- Moradi, F.; Ghaedi, A.; Fooladfar, Z.; Bazrgar, A. Recent advance on nanoparticles or nanomaterials with anti-multidrug resistant bacteria and anti-bacterial biofilm properties: A systematic review. Heliyon 2023, 9, e22105. [Google Scholar] [CrossRef] [PubMed]
- Makabenta, J.M.V.; Nabawy, A.; Li, C.H.; Schmidt-Malan, S.; Patel, R.; Rotello, V.M. Nanomaterial-based therapeutics for antibiotic-resistant bacterial infections. Nat. Rev. Microbiol. 2021, 19, 23–36. [Google Scholar] [CrossRef]
- Kumar, P.; Huo, P.P.; Zhang, R.Z.; Liu, B. Antibacterial Properties of Graphene-Based Nanomaterials. Nanomaterials 2019, 9, 737. [Google Scholar] [CrossRef] [PubMed]
- Frei, A.; Verderosa, A.D.; Elliott, A.G.; Zuegg, J.; Blaskovich, M.A.T. Metals to combat antimicrobial resistance. Nat. Rev. Chem. 2023, 7, 202–224. [Google Scholar] [CrossRef] [PubMed]
- Badoni, A.; Prakash, J. Noble metal nanoparticles and graphene oxide based hybrid nanostructures for antibacterial applications: Recent advances, synergistic antibacterial activities, and mechanistic approaches. Micro Nano Eng. 2024, 22, 100239. [Google Scholar] [CrossRef]
- Ji, H.; Sun, H.; Qu, X. Antibacterial applications of graphene-based nanomaterials: Recent achievements and challenges. Adv. Drug Deliv. Rev. 2016, 105, 176–189. [Google Scholar] [CrossRef] [PubMed]
- Lee, J.; Kim, J.; Kim, S.; Min, D.-H. Biosensors based on graphene oxide and its biomedical application. Adv. Drug Deliv. Rev. 2016, 105, 275–287. [Google Scholar] [CrossRef]
- Choi, S.; Kim, C.; Suh, J.M.; Jang, H.W. Reduced graphene oxide-based materials for electrochemical energy conversion reactions. Carbon Energy 2019, 1, 85–108. [Google Scholar] [CrossRef]
- Thakur, K.; Kandasubramanian, B. Graphene and Graphene Oxide-Based Composites for Removal of Organic Pollutants: A Review. J. Chem. Eng. Data 2019, 64, 833–867. [Google Scholar] [CrossRef]
- Chavez, R.O.; Lodge, T.P.; Huitron, J.; Chipara, M.; Alcoutlabi, M. Centrifugally spun carbon fibers prepared from aqueous poly(vinylpyrrolidone) solutions as binder-free anodes in lithium-ion batteries. J. Appl. Polym. Sci. 2021, 138, 50396. [Google Scholar] [CrossRef]
- Flores, D.; Villarreal, J.; Lopez, J.; Alcoutlabi, M. Production of carbon fibers through Forcespinning® for use as anode materials in sodium ion batteries. Mater. Sci. Eng. B Adv. 2018, 236, 70–75. [Google Scholar] [CrossRef]
- Worku, A.K.; Ayele, D.W. Recent advances of graphene-based materials for emerging technologies. Results Chem. 2023, 5, 100971. [Google Scholar] [CrossRef]
- Xu, M.S.; Liang, T.; Shi, M.M.; Chen, H.Z. Graphene-Like Two-Dimensional Materials. Chem. Rev. 2013, 113, 3766–3798. [Google Scholar] [CrossRef]
- Ji, L.W.; Meduri, P.; Agubra, V.; Xiao, X.C.; Alcoutlabi, M. Graphene-Based Nanocomposites for Energy Storage. Adv. Energy Mater. 2016, 6, 1502159. [Google Scholar] [CrossRef]
- Smith, A.T.; LaChance, A.M.; Zeng, S.S.; Liu, B.; Sun, L.Y. Synthesis, properties, and applications of graphene oxide/reduced graphene oxide and their nanocomposites. Nano Mater. Sci. 2019, 1, 31–47. [Google Scholar] [CrossRef]
- Liu, S.B.; Zeng, T.H.; Hofmann, M.; Burcombe, E.; Wei, J.; Jiang, R.R.; Kong, J.; Chen, Y. Antibacterial Activity of Graphite, Graphite Oxide, Graphene Oxide, and Reduced Graphene Oxide: Membrane and Oxidative Stress. ACS Nano 2011, 5, 6971–6980. [Google Scholar] [CrossRef] [PubMed]
- Yaragalla, S.; Bhavitha, K.B.; Athanassiou, A. A Review on Graphene Based Materials and Their Antimicrobial Properties. Coatings 2021, 11, 1197. [Google Scholar] [CrossRef]
- Rhazouani, A.; Gamrani, H.; El Achaby, M.; Aziz, K.; Gebrati, L.; Uddin, M.S.; Aziz, F. Synthesis and toxicity of graphene oxide nanoparticles: A literature review of in vitro and in vivo studies. BioMed Res. Int. 2021, 2021, 5518999. [Google Scholar] [CrossRef]
- Zheng, H.; Ma, R.; Gao, M.; Tian, X.; Li, Y.-Q.; Zeng, L.; Li, R. Antibacterial applications of graphene oxides: Structure-activity relationships, molecular initiating events and biosafety. Sci. Bull. 2018, 63, 133–142. [Google Scholar] [CrossRef]
- Pulingam, T.; Thong, K.L.; Ali, M.E.; Appaturi, J.N.; Dinshaw, I.J.; Ong, Z.Y.; Leo, B.F. Graphene oxide exhibits differential mechanistic action towards Gram-positive and Gram-negative bacteria. Colloids Surf. B Biointerfaces 2019, 181, 6–15. [Google Scholar] [CrossRef] [PubMed]
- Gurunathan, S.; Han, J.W.; Dayem, A.A.; Eppakayala, V.; Kim, J.-H. Oxidative stress-mediated antibacterial activity of graphene oxide and reduced graphene oxide in Pseudomonas aeruginosa. Int. J. Nanomed. 2012, 7, 5901–5914. [Google Scholar] [CrossRef] [PubMed]
- Liao, K.-H.; Lin, Y.-S.; Macosko, C.W.; Haynes, C.L. Cytotoxicity of graphene oxide and graphene in human erythrocytes and skin fibroblasts. ACS Appl. Mater. Interfaces 2011, 3, 2607–2615. [Google Scholar] [CrossRef]
- Li, M.N.; Chen, Z.F.; Yang, L.X.; Li, J.Y.; Xu, J.; Chen, C.; Wu, Q.; Yang, M.M.; Liu, T.L. Antibacterial Activity and Mechanism of GO/CuO/ZnO Coating on Ultrafine Glass Fiber. Nanomaterials 2022, 12, 1857. [Google Scholar] [CrossRef]
- Mohammed, H.; Kumar, A.; Bekyarova, E.; Al-Hadeethi, Y.; Zhang, X.X.; Chen, M.G.; Ansari, M.S.; Cochis, A.; Rimondini, L. Antimicrobial Mechanisms and Effectiveness of Graphene and Graphene-Functionalized Biomaterials. A Scope Review. Front. Bioeng. Biotech. 2020, 8, 465. [Google Scholar] [CrossRef]
- Liu, J.J.; Hull, S.; Ahmed, I.; Skinner, S.J. Application of combined neutron diffraction and impedance spectroscopy for structure and conductivity studies of LaMoO. Nucl. Instrum. Meth. B 2011, 269, 539–543. [Google Scholar] [CrossRef]
- Gold, K.; Slay, B.; Knackstedt, M.; Gaharwar, A.K. Antimicrobial Activity of Metal and Metal-Oxide Based Nanoparticles. Adv. Ther. 2018, 1, 1700033. [Google Scholar] [CrossRef]
- Li, Y.; Zhang, W.; Niu, J.; Chen, Y. Mechanism of Photogenerated Reactive Oxygen Species and Correlation with the Antibacterial Properties of Engineered Metal-Oxide Nanoparticles. ACS Nano 2012, 6, 5164–5173. [Google Scholar] [CrossRef]
- Nanda, S.S.; Yi, D.K.; Kim, K. Study of antibacterial mechanism of graphene oxide using Raman spectroscopy. Sci. Rep. 2016, 6, 28443. [Google Scholar] [CrossRef] [PubMed]
- Henriques, P.C.; Borges, I.; Pinto, A.M.; Magalhães, F.D.; Gonçalves, I.C. Fabrication and antimicrobial performance of surfaces integrating graphene-based materials. Carbon 2018, 132, 709–732. [Google Scholar] [CrossRef]
- Dadi, R.; Azouani, R.; Traore, M.; Mielcarek, C.; Kanaev, A. Antibacterial activity of ZnO and CuO nanoparticles against gram positive and gram negative strains. Mater. Sci. Eng. C 2019, 104, 109968. [Google Scholar] [CrossRef] [PubMed]
- Hasan, M.T.; Gonzalez, R.; Munoz, A.A.; Materon, L.; Parsons, J.G.; Alcoutlabi, M. Forcespun polyvinylpyrrolidone/copper and polyethylene oxide/copper composite fibers and their use as antibacterial agents. J. Appl. Polym. Sci. 2022, 139, 51773. [Google Scholar] [CrossRef]
- Hasan, M.T.; Gonzalez, R.; Chipara, M.; Materon, L.; Parsons, J.; Alcoutlabi, M. Antibacterial activities of centrifugally spun polyethylene oxide/silver composite nanofibers. Polym. Adv. Technol. 2021, 32, 2327–2338. [Google Scholar] [CrossRef]
- De la Garza, D.; De Santiago, F.; Materon, L.; Chipara, M.; Alcoutlabi, M. Fabrication and characterization of centrifugally spun poly(acrylic acid) nanofibers. J. Appl. Polym. Sci. 2019, 136, 47480. [Google Scholar] [CrossRef]
- Smijs, T.G.; Pavel, S. Titanium dioxide and zinc oxide nanoparticles in sunscreens: Focus on their safety and effectiveness. Nanotechnol. Sci. Appl. 2011, 4, 95–112. [Google Scholar] [CrossRef] [PubMed]
- Fortunato, E.; Gonçalves, A.; Pimentel, A.; Barquinha, P.; Gonçalves, G.; Pereira, L.; Ferreira, I.; Martins, R. Zinc oxide, a multifunctional material: From material to device applications. Appl. Phys. A 2009, 96, 197–205. [Google Scholar] [CrossRef]
- Espitia, P.J.P.; Soares, N.d.F.F.; Coimbra, J.S.d.R.; de Andrade, N.J.; Cruz, R.S.; Medeiros, E.A.A. Zinc oxide nanoparticles: Synthesis, antimicrobial activity and food packaging applications. Food Bioprocess Technol. 2012, 5, 1447–1464. [Google Scholar] [CrossRef]
- Franco, D.; Calabrese, G.; Guglielmino, S.P.P.; Conoci, S. Metal-Based Nanoparticles: Antibacterial Mechanisms and Biomedical Application. Microorganisms 2022, 10, 1778. [Google Scholar] [CrossRef] [PubMed]
- Anedda, E.; Farrell, M.L.; Morris, D.; Burgess, C.M. Evaluating the impact of heavy metals on antimicrobial resistance in the primary food production environment: A scoping review. Environ. Pollut. 2023, 320, 121035. [Google Scholar] [CrossRef]
- Kadiyala, U.; Kotov, N.A.; VanEpps, J.S. Antibacterial Metal Oxide Nanoparticles: Challenges in Interpreting the Literature. Curr. Pharm. Des. 2018, 24, 896–903. [Google Scholar] [CrossRef]
- Du, J.; Tang, J.H.; Xu, S.D.; Ge, J.Y.; Dong, Y.W.; Li, H.X.; Jin, M.Q. ZnO nanoparticles: Recent advances in ecotoxicity and risk assessment. Drug Chem. Toxicol. 2020, 43, 322–333. [Google Scholar] [CrossRef] [PubMed]
- Raha, S.; Ahmaruzzaman, M. ZnO nanostructured materials and their potential applications: Progress, challenges and perspectives. Nanoscale Adv. 2022, 4, 1868–1925. [Google Scholar] [CrossRef] [PubMed]
- Rihova, M.; Cihalova, K.; Pouzar, M.; Kuthanova, M.; Jelinek, L.; Hromadko, L.; Cicmancova, V.; Heger, Z.; Macak, J.M. Biopolymeric fibers prepared by centrifugal spinning blended with ZnO nanoparticles for the treatment of Acne vulgaris. Appl. Mater. Today 2024, 37, 102151. [Google Scholar] [CrossRef]
- Mohd Yusof, H.; Abdul Rahman, N.A.; Mohamad, R.; Hasanah Zaidan, U.; Samsudin, A.A. Antibacterial Potential of Biosynthesized Zinc Oxide Nanoparticles against Poultry-Associated Foodborne Pathogens: An In Vitro Study. Animals 2021, 11, 2093. [Google Scholar] [CrossRef] [PubMed]
- Mendes, C.R.; Dilarri, G.; Forsan, C.F.; Sapata, V.d.M.R.; Lopes, P.R.M.; de Moraes, P.B.; Montagnolli, R.N.; Ferreira, H.; Bidoia, E.D. Antibacterial action and target mechanisms of zinc oxide nanoparticles against bacterial pathogens. Sci. Rep. 2022, 12, 2658. [Google Scholar] [CrossRef] [PubMed]
- Zhou, X.; Shi, T.; Zhou, H. Hydrothermal preparation of ZnO-reduced graphene oxide hybrid with high performance in photocatalytic degradation. Appl. Surf. Sci. 2012, 258, 6204–6211. [Google Scholar] [CrossRef]
- Kumar, P.; Som, S.; Pandey, M.K.; Das, S.; Chanda, A.; Singh, J. Investigations on optical properties of ZnO decorated graphene oxide (ZnO@GO) and reduced graphene oxide (ZnO@r-GO). J. Alloys Compd. 2018, 744, 64–74. [Google Scholar] [CrossRef]
- Chung, K.; Lee, C.-H.; Yi, G.-C. Transferable GaN Layers Grown on ZnO-Coated Graphene Layers for Optoelectronic Devices. Science 2010, 330, 655–657. [Google Scholar] [CrossRef] [PubMed]
- Lee, J.M.; Pyun, Y.B.; Yi, J.; Choung, J.W.; Park, W.I. ZnO Nanorod−Graphene Hybrid Architectures for Multifunctional Conductors. J. Phys. Chem. C 2009, 113, 19134–19138. [Google Scholar] [CrossRef]
- Mao, J.; Li, J.J.; Ling, T.; Liu, H.; Yang, J.; Du, X.W. Facile synthesis of zinc hydroxide carbonate flowers on zinc oxide nanorods with attractive luminescent and optochemical performance. Nanotechnology 2011, 22, 245607. [Google Scholar] [CrossRef]
- Du, Y.Q.; Li, G.Y.; Ye, L.; Che, C.J.; Yang, X.H.; Zhao, L.J. Sandwich-like Ni-Zn hydroxide nanosheets vertically aligned on reduced graphene oxide via MOF templates towards boosting supercapacitive performance. Chem. Eng. J. 2021, 417, 129189. [Google Scholar] [CrossRef]
- Nabipour, H.; Sadr, M.H.; Thomas, N. Synthesis, characterisation and sustained release properties of layered zinc hydroxide intercalated with amoxicillin trihydrate. J. Exp. Nanosci. 2015, 10, 1269–1284. [Google Scholar] [CrossRef]
- Flores, K.; Valdes, C.; Ramirez, D.; Eubanks, T.M.; Lopez, J.; Hernandez, C.; Alcoutlabi, M.; Parsons, J.G. The effect of hybrid zinc oxide/graphene oxide (ZnO/GO) nano-catalysts on the photocatalytic degradation of simazine. Chemosphere 2020, 259, 127414. [Google Scholar] [CrossRef] [PubMed]
- Kumar, P.; Penta, S.; Mahapatra, S.P. Dielectric Properties of Graphene Oxide Synthesized by Modified Hummers’ Method from Graphite Powder. Integr. Ferroelectr. 2019, 202, 41–51. [Google Scholar] [CrossRef]
- Shahriary, L.; Athawale, A.A. Graphene oxide synthesized by using modified hummers approach. Int. J. Renew. Energy Environ. Eng. 2014, 2, 58–63. [Google Scholar]
- Sun, H.J.; Yang, Y.H.; Huang, Q. Preparation and Structural Variation of Graphite Oxide and Graphene Oxide. Integr. Ferroelectr. 2011, 128, 163–170. [Google Scholar] [CrossRef]
- Lee, D.W.; De Los Santos, L.; Seo, J.W.; Felix, L.L.; Bustamante, A.; Cole, J.M.; Barnes, C.H.W. The Structure of Graphite Oxide: Investigation of Its Surface Chemical Groups. J. Phys. Chem. B 2010, 114, 5723–5728. [Google Scholar] [CrossRef] [PubMed]
- Wang, H.; Hu, Y.H. Effect of Oxygen Content on Structures of Graphite Oxides. Ind. Eng. Chem. Res. 2011, 50, 6132–6137. [Google Scholar] [CrossRef]
- Morales, H.M.; Vieyra, H.; Sanchez, D.A.; Fletes, E.M.; Odlyzko, M.; Lodge, T.P.; Padilla-Gainza, V.; Alcoutlabi, M.; Parsons, J.G. Synthesis and Characterization of Titanium Nitride–Carbon Composites and Their Use in Lithium-Ion Batteries. Nanomaterials 2024, 14, 624. [Google Scholar] [CrossRef]
- Gordeeva, A.; Hsu, Y.-J.; Jenei, I.Z.; Brant Carvalho, P.H.B.; Simak, S.I.; Andersson, O.; Häussermann, U. Layered Zinc Hydroxide Dihydrate, Zn5(OH)10·2H2O, from Hydrothermal Conversion of ε-Zn(OH)2 at Gigapascal Pressures and its Transformation to Nanocrystalline ZnO. ACS Omega 2020, 5, 17617–17627. [Google Scholar] [CrossRef]
- Botez, C.E.; Morris, J.L.; Manriquez, A.J.E.; Anchondo, A. Heating induced structural and chemical behavior of KDPO in the 25 °C–215 °C temperature range. Mater. Charact. 2013, 83, 74–78. [Google Scholar] [CrossRef]
- Morales, H.M.; Vieyra, H.; Sanchez, D.A.; Fletes, E.M.; Odlyzko, M.; Lodge, T.P.; Padilla-Gainza, V.; Alcoutlabi, M.; Parsons, J.G. Synthesis and Characterization of Vanadium Nitride/Carbon Nanocomposites. Int. J. Mol. Sci. 2024, 25, 6952. [Google Scholar] [CrossRef] [PubMed]
- Rani, J.R.; Lim, J.; Oh, J.; Kim, D.; Lee, D.; Kim, J.-W.; Shin, H.S.; Kim, J.H.; Jun, S.C. Substrate and buffer layer effect on the structural and optical properties of graphene oxide thin films. RSC Adv. 2013, 3, 5926–5936. [Google Scholar] [CrossRef]
- Gupta, B.; Kumar, N.; Panda, K.; Kanan, V.; Joshi, S.; Visoly-Fisher, I. Role of oxygen functional groups in reduced graphene oxide for lubrication. Sci. Rep. 2017, 7, 45030. [Google Scholar] [CrossRef] [PubMed]
- Al-Gaashani, R.; Najjar, A.; Zakaria, Y.; Mansour, S.; Atieh, M.A. XPS and structural studies of high quality graphene oxide and reduced graphene oxide prepared by different chemical oxidation methods. Ceram. Int. 2019, 45, 14439–14448. [Google Scholar] [CrossRef]
- Jnido, G.; Ohms, G.; Viöl, W. Deposition of zinc oxide coatings on wood surfaces using the solution precursor plasma spraying process. Coatings 2021, 11, 183. [Google Scholar] [CrossRef]
- Lin, B.C.; Shen, P.; Chen, S.Y. ZnO and epsilon-Zn(OH)(2) Composite Nanoparticles by Pulsed Laser Ablation on Zn in Water. J. Phys. Chem. C 2011, 115, 5003–5010. [Google Scholar] [CrossRef]
- Wang, M.S.; Jiang, L.X.; Kim, E.J.; Hahn, S.H. Electronic structure and optical properties of Zn(OH)(2): LDA+U calculations and intense yellow luminescence. RSC Adv. 2015, 5, 87496–87503. [Google Scholar] [CrossRef]
- Sitko, R.; Turek, E.; Zawisza, B.; Malicka, E.; Talik, E.; Heimann, J.; Gagor, A.; Feist, B.; Wrzalik, R. Adsorption of divalent metal ions from aqueous solutions using graphene oxide. Dalton Trans. 2013, 42, 5682–5689. [Google Scholar] [CrossRef]
- Kasaeian, M.; Ghasemi, E.; Ramezanzadeh, B.; Mahdavian, M.; Bahlakeh, G. A combined experimental and electronic-structure quantum mechanics approach for studying the kinetics and adsorption characteristics of zinc nitrate hexahydrate corrosion inhibitor on the graphene oxide nanosheets. Appl. Surf. Sci. 2018, 462, 963–979. [Google Scholar] [CrossRef]
- Seredych, M.; Mabayoje, O.; Kolesnik, M.M.; Krstic, V.; Bandosz, T.J. Zinc (hydr)oxide/graphite based-phase composites: Effect of the carbonaceous phase on surface properties and enhancement in electrical conductivity. J. Mater. Chem. 2012, 22, 7970–7978. [Google Scholar] [CrossRef]
- Kumar, A.; Joseph, S.; Tsechansky, L.; Privat, K.; Schreiter, I.J.; Schüth, C.; Graber, E.R. Biochar aging in contaminated soil promotes Zn immobilization due to changes in biochar surface structural and chemical properties. Sci. Total Environ. 2018, 626, 953–961. [Google Scholar] [CrossRef] [PubMed]
- Mandal, P.; Ghosh, S.K.; Grewal, H.S. Graphene oxide coated aluminium as an efficient antibacterial surface. Environ. Technol. Innov. 2022, 28, 102591. [Google Scholar] [CrossRef]
- Menazea, A.A.; Ahmed, M.K. Synthesis and antibacterial activity of graphene oxide decorated by silver and copper oxide nanoparticles. J. Mol. Struct. 2020, 1218, 128536. [Google Scholar] [CrossRef]
- Emami-Karvani, Z.; Chehrazi, P. Antibacterial activity of ZnO nanoparticle on gram-positive and gram-negative bacteria. Afr. J. Microbiol. Res. 2011, 5, 1368–1373. [Google Scholar]
- Jones, N.; Ray, B.; Ranjit, K.T.; Manna, A.C. Antibacterial activity of ZnO nanoparticle suspensions on a broad spectrum of microorganisms. FEMS Microbiol. Lett. 2008, 279, 71–76. [Google Scholar] [CrossRef] [PubMed]
- Bouttier-Figueroa, D.C.; Garcia-Valenzuela, J.A.; Cabrera-German, D.; Cota-Leal, M.; Quevedo-Lopez, M.A.; Rosas-Durazo, A.; Sotelo-Lerma, M. Characterization of the antibacterial galactomannan/Zn(OH)(2)-ZnO composite material prepared from a green process using mesquite seeds as a biopolymer source. Bull. Mater. Sci. 2019, 42, 116. [Google Scholar] [CrossRef]
- Khafri, H.Z.; Ghaedi, M.; Asfaram, A.; Javadian, H.; Safarpoor, M. Synthesis of CuS and ZnO/Zn(OH)(2) nanoparticles and their evaluation for in vitro antibacterial and antifungal activities. Appl. Organomet. Chem. 2018, 32, e4398. [Google Scholar] [CrossRef]
- Haque, S.; Faidah, H.; Ashgar, S.S.; Abujamel, T.S.; Mokhtar, J.A.; Almuhayawi, M.S.; Harakeh, S.; Singh, R.; Srivastava, N.; Gupta, V.K. Green Synthesis of Zn(OH)(2)/ZnO-Based Bionanocomposite using Pomegranate Peels and Its Application in the Degradation of Bacterial Biofilm. Nanomaterials 2022, 12, 3458. [Google Scholar] [CrossRef]
- Awassa, J.; Soule, S.; Cornu, D.; Ruby, C.; El-Kirat-Chatel, S. Understanding the role of surface interactions in the antibacterial activity of layered double hydroxide nanoparticles by atomic force microscopy. Nanoscale 2022, 14, 10335–10348. [Google Scholar] [CrossRef]
- Tariq, M.; Khan, A.U.; Rehman, A.U.; Ullah, S.; Jan, A.U.; Zakareya; Khan, Z.U.; Muhammad, N.; Ul Islam, Z.; Yuan, Q.P. Green synthesis of Zno@GO nanocomposite and its’ efficient antibacterial activity. Photodiagn. Photodyn. Ther. 2021, 35, 102471. [Google Scholar] [CrossRef] [PubMed]
- Hsueh, Y.H.; Hsieh, C.T.; Chiu, S.T.; Tsai, P.H.; Liu, C.Y.; Ke, W.J. Antibacterial Property of Composites of Reduced Graphene Oxide with Nano-Silver and Zinc Oxide Nanoparticles Synthesized Using a Microwave-Assisted Approach. Int. J. Mol. Sci. 2019, 20, 5394. [Google Scholar] [CrossRef] [PubMed]
- Sahin, E.; Musevi, S.J.; Aslani, A. Antibacterial activity against and characterization of ZnO and ZnO-AlO mixed oxide nanoparticles. Arab. J. Chem. 2017, 10, S230–S235. [Google Scholar] [CrossRef]
- Ahmadi, R.; Nafchi, R.F.; Sangpour, P.; Bagheri, M.; Badiei, E. A comparative study: Green synthesis and evaluation of ZnO-GO and ZnO-RGO nanocomposites for antibacterial applications. Mater. Sci. Eng. B Adv. 2023, 294, 116555. [Google Scholar] [CrossRef]
- Prasad, K.; Lekshmi, G.S.; Ostrikov, K.; Lussini, V.; Blinco, J.; Mohandas, M.; Vasilev, K.; Bottle, S.; Bazaka, K.; Ostrikov, K. Synergic bactericidal effects of reduced graphene oxide and silver nanoparticles against Gram-positive and Gram-negative bacteria. Sci. Rep. 2017, 7, 1591. [Google Scholar] [CrossRef]
- Karaky, N.; Tang, S.Y.; Ramalingam, P.; Kirby, A.; McBain, A.J.; Banks, C.E.; Whitehead, K.A. Multidrug-Resistant Remains Susceptible to Metal Ions and Graphene-Based Compounds. Antibiotics 2024, 13, 381. [Google Scholar] [CrossRef]

| Sample | Element (Shell) | Weight (%) | Atomic (%) | Net Int. | Error (%) | Kratio | Z | A | F |
|---|---|---|---|---|---|---|---|---|---|
| GO | C(K) | 58.24 | 65.01 | 637.70 | 3.86 | 0.48 | 1.02 | 0.81 | 1.00 |
| O (K) | 41.76 | 34.99 | 351.20 | 7.88 | 0.17 | 0.97 | 0.43 | 1.00 | |
| GO-25% Zn (OH)x | C (K) | 58.88 | 71.86 | 593.00 | 5.73 | 0.39 | 1.06 | 0.62 | 1.00 |
| O (K) | 27.34 | 25.05 | 253.90 | 8.39 | 0.11 | 1.00 | 0.40 | 1.00 | |
| Zn (L) | 13.77 | 3.09 | 121.60 | 3.24 | 0.09 | 0.72 | 0.95 | 1.00 | |
| GO-50% Zn (OH)x | C (K) | 33.93 | 54.48 | 410.00 | 7.96 | 0.16 | 1.15 | 0.40 | 1.00 |
| O (K) | 28.59 | 34.46 | 595.20 | 7.28 | 0.15 | 1.09 | 0.48 | 1.00 | |
| Zn (L) | 37.47 | 11.06 | 607.50 | 2.78 | 0.27 | 0.78 | 0.93 | 1.00 | |
| GO-75% Zn (OH)x | C (K) | 40.89 | 60.69 | 654.60 | 7.47 | 0.21 | 1.13 | 0.45 | 1.00 |
| O (K) | 27.56 | 30.71 | 650.40 | 7.48 | 0.13 | 1.07 | 0.45 | 1.00 | |
| Zn (L) | 31.54 | 8.60 | 614.40 | 2.69 | 0.23 | 0.77 | 0.94 | 1.00 |
| Sample | Phase | Space Group | a (Å) | b (Å) | c (Å) | α (°) | β (°) | γ (°) | χ2 |
|---|---|---|---|---|---|---|---|---|---|
| Zn-75-G.O. | Zn5(OH)102H2O | C2/c | 15.32 (3) | 6.10 (1)0 | 10.96 (2) | 90.00 | 99.10 | 90.00 | 2.03 |
| ϵ-Zn (OH)2 | P212121 | 4.18 (5) | 5.04 (8) | 8.52 (4) | 90.00 | 90.00 | 90.00 | ||
| G.O. | P63mc | 2.48 (4) | 2.48 (4) | 16.62 | 90.00 | 90.00 | 120.00 | ||
| Graphene Oxide | G.O. | P63mc | 90.00 | 90.00 | 120.00 | 1.13 | |||
| Graphite | P63mc | 2.45 (3) | 2.45 (3) | 6.64 (9) | 90.00 | 90.00 | 120.00 |
| B. megaterium | E. coli | |||
|---|---|---|---|---|
| % Coating | Zone of Inhibition | Standard Deviation | Zone of Inhibition | Standard Deviation |
| 0 | 1.9277 | 0.118541 | 1.3372 | 0.066645 |
| 25 | 2.6266 | 0.089994 | 1.8097 | 0.048761 |
| 50 | 2.9097 | 0.069652 | 1.9962 | 0.057996 |
| 75 | 4.8273 | 0.127387 | 2.4175 | 0.08373 |
Disclaimer/Publisher’s Note: The statements, opinions and data contained in all publications are solely those of the individual author(s) and contributor(s) and not of MDPI and/or the editor(s). MDPI and/or the editor(s) disclaim responsibility for any injury to people or property resulting from any ideas, methods, instructions or products referred to in the content. |
© 2024 by the authors. Licensee MDPI, Basel, Switzerland. This article is an open access article distributed under the terms and conditions of the Creative Commons Attribution (CC BY) license (https://creativecommons.org/licenses/by/4.0/).
Share and Cite
Sanchez, J.A.; Materon, L.; Parsons, J.G.; Alcoutlabi, M. Synthesis, Characterization, and Antibacterial Activity of Graphene Oxide/Zinc Hydroxide Nanocomposites. Appl. Sci. 2024, 14, 6274. https://doi.org/10.3390/app14146274
Sanchez JA, Materon L, Parsons JG, Alcoutlabi M. Synthesis, Characterization, and Antibacterial Activity of Graphene Oxide/Zinc Hydroxide Nanocomposites. Applied Sciences. 2024; 14(14):6274. https://doi.org/10.3390/app14146274
Chicago/Turabian StyleSanchez, Jo Ann, Luis Materon, Jason G. Parsons, and Mataz Alcoutlabi. 2024. "Synthesis, Characterization, and Antibacterial Activity of Graphene Oxide/Zinc Hydroxide Nanocomposites" Applied Sciences 14, no. 14: 6274. https://doi.org/10.3390/app14146274
APA StyleSanchez, J. A., Materon, L., Parsons, J. G., & Alcoutlabi, M. (2024). Synthesis, Characterization, and Antibacterial Activity of Graphene Oxide/Zinc Hydroxide Nanocomposites. Applied Sciences, 14(14), 6274. https://doi.org/10.3390/app14146274








